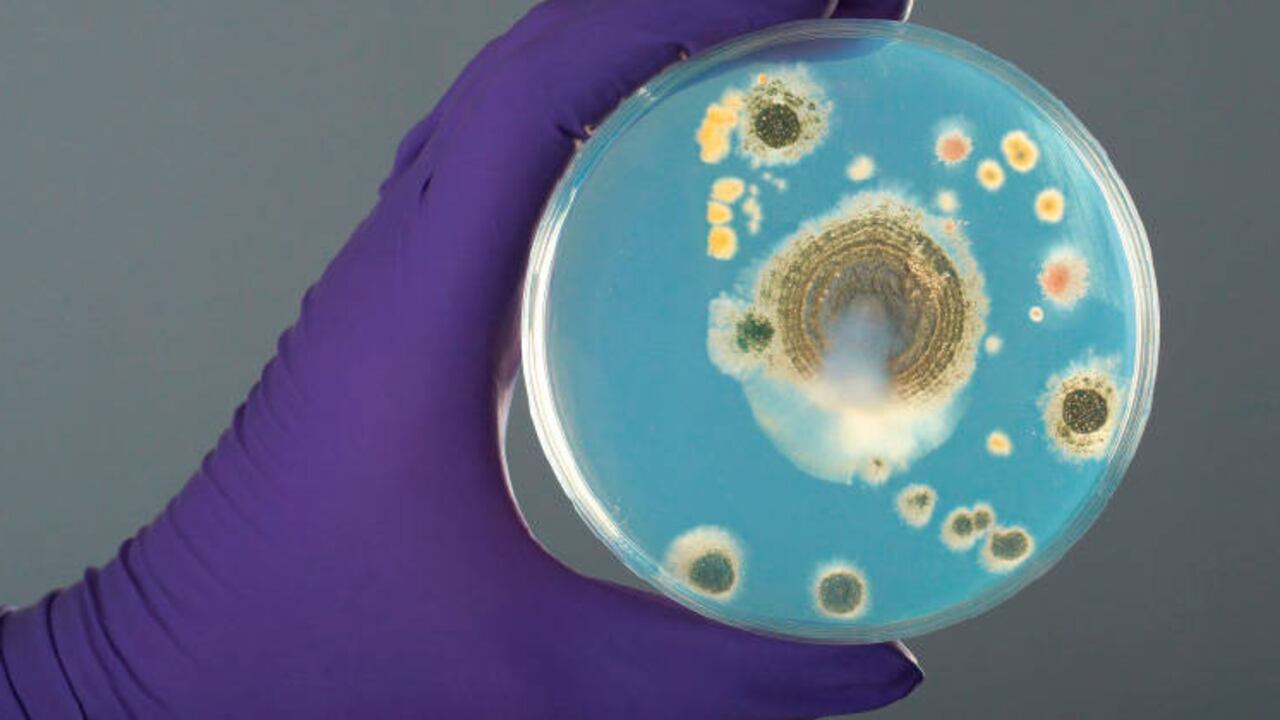

El coronavirus ha impactado a todo el mundo y ha generado inquietud en muchos hogares de cómo evitar la propagación del covid-19 en casa. Las medidas higiénicas han aumentado y es aconsejable, aunque no obligatorio, crear una rutina especial de limpieza para esos objetos personales que sacamos a la calle. En este contexto la mejor recomendación para romper esta cadena es lavarse las manos con más frecuencia y más a fondo, y evitar tocar esos objetos cotidianos y luego, tocarnos la cara.
En términos de prevención, la limpieza y desinfección son primordiales "la limpieza de las superficies más usadas además de su desinfección es una de las mejores medidas para la prevención de la covid-19", explica Gerardo Montoiro, gerente de Bisbell España, dedicados a la limpieza de suelos desde 1876.
"Limpiar ayuda a reducir el riesgo de propagación de gérmenes y bacterias, pero, además, usar un desinfectante después de esto ayuda a mejorar y prevenir contagios", comentan desde la firma.
Los objetos más frecuentes como las gafas, los móviles, el mando de la televisión, las llaves de casa o los juguetes deben limpiarse y desinfectarse diariamente. Según la Organización Mundial de la Salud (OMS), no se sabe con certeza cuánto tiempo sobrevive en la superficie de un objeto como pueden ser el móvil, las monedas o los billetes... De acuerdo con la información que se conoce hasta el momento, el coronavirus podría subsistir desde unas pocas horas hasta varios días, según el tipo de superficie, la temperatura, la humedad del objeto que sea.
"Para desinfectarlos, cuando el material lo permita, es mejor usar un paño limpio con solución hidroalcohólica. También se podría limpiar con agua y jabón, recuerda que la limpieza con vapor elimina gérmenes, suciedad e impurezas gracias a su poder desinfectante", añade Montoiro.
Asimismo, la empresa de limpieza han notado el incremento de consultas por productos de limpieza al vapor "en definitiva es un buen aliado en cualquier desinfección".
CÓMO DESINFECTAR POMOS Y MANECILLAS DE PUERTAS, VENTANAS O ARMARIOS
Son zonas que se tocan con frecuencia. Al igual que los interruptores. Siempre que se accede al hogar lavarse bien las manos antes de tocar nada dentro de la casa. Si no ha sido posible lo mejor es primero limpiar estos objetos y luego, desinfectarlos. "Si primero no hay limpieza, la desinfección no es efectiva", explica Montoiro.
CÓMO DESINFECTAR LAS LLAVES DE CASA
Las llaves siempre las tocamos tanto para salir como para entrar. Posiblemente, es el objeto que más expuesto está a las bacterias. Lo mejor es nada más entrar a casa limpiarlas con agua templada y jabón o con limpieza al vapor.
CÓMO DESINFECTAR EL MÓVIL
¿Cuántas veces podemos tocar el móvil? Llamadas, mensajes, leer noticias. Aunque las manos estén limpias si no has desinfectado el móvil, no sirve de nada porque es posible que el móvil pueda transferir eses gérmenes de nuevo a las manos. "Hay estudios que confirman que los móviles tienen más bacterias que un inodoro", añade Montoiro.
Para limpiar correctamente el teléfono sin correr el riesgo de causar daños por agua es preferible seguir las recomendaciones e instrucciones de la marca. Lo importante es mantener siempre las manos limpias antes de limpiar la superficie, elige un buen paño de microfibra antibacteriano y límpialo tras cada uso y más si sale fuera del hogar.
CÓMO DESINFECTAR GAFAS
Ya sean de vista o de sol, las gafas son el complemento que siempre nos acompañan. Por eso, es conveniente lavarlas con frecuencia ya que están expuestas diariamente.
CÓMO DESINFECTAR JUGUETES
En unas horas establecidas, los niños ya pueden salir a la calle y pueden llevarse juguetes. Es recomendable que, a la vuelta, los objetos con los que jueguen en la calle se laven con agua caliente y jabón. Hay que tener especial cuidado y prevenir siempre.
No siempre es posible eliminar el 100 por ciento de las bacterias de todo lo que se toca, pero el jabón y el agua, los limpiadores hidroalcohólicos, la limpieza al vapor son los métodos más efectivos y, ante todo, estos especialistas recomiendan que siempre hay que usar guantes y ropa específica destinada a la limpieza, "lavar bien la ropa y trapos usados con programas de agua caliente, al igual que desinfectar o lavar los estropajos de la cocina frecuentemente, ya que pueden acumular gérmenes".